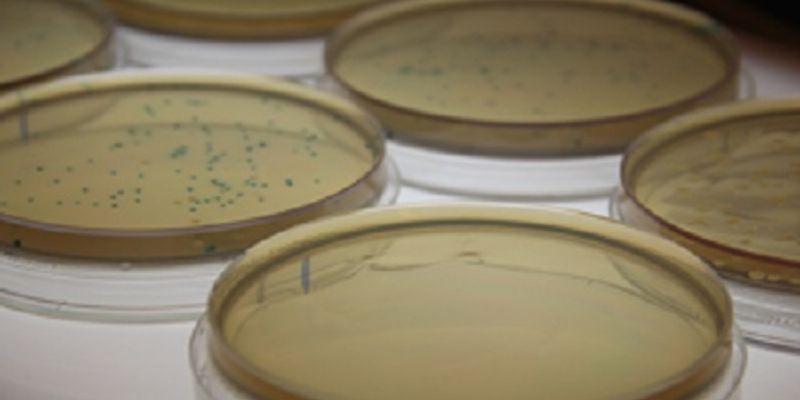

Colony PCR
Colony PCR: Colony PCR is a method used to screen for plasmids containing a desired insert directly from bacterial colonies without the need for culturing or plasmid purification steps. It is a convenient high-throughput method for determining the presence or absence of insert DNA in plasmid constructs.
What's Popular in Colony PCR
-
AUG 15, 2023MicrobiologyAbstract In this study, we used Sartorius Real-time PCR kits for the rapid detection of bacteria, fungi, and mycoplasma ...JAN 09, 2022Cannabis SciencesAs commercial cannabis continues to gain traction in the market and popularity among consumers, the need to establish qu ...Written By: Nadine HusamiOCT 19, 2018Plants & AnimalsAnts, fascinating social insects, studying their foraging behavior reveals valuable information.Written By: Aswini Kanneganti
AUG 15, 2023
Microbiology
Abstract In this study, we used Sartorius Real-time PCR kits for the rapid detection of bacteria, fungi, and mycoplasma
...
JAN 09, 2022
Cannabis Sciences
As commercial cannabis continues to gain traction in the market and popularity among consumers, the need to establish qu
...
Written By:
Nadine Husami
OCT 19, 2018
Plants & Animals
Ants, fascinating social insects, studying their foraging behavior reveals valuable information.
Written By:
Aswini Kanneganti
-
OCT 13, 2022 | 9:00 AMFirst Broadcast: Date: October 12, 2022 Time: 8:00am PDT, 11:00am EDT Second Broadcast: Date: October 12, 2022 Time: 9:00am SGT The new Embedded CryoSPARC Live, now fully integrated with t...Speaker: Julio Ortiz , Edward Pryor, PhD , Ali PunjaniPresented at: Thermo Fisher Scientific - Electron Microscopy Webinars
Sponsored By: Thermo Fisher ScientificAUG 10, 2022 | 10:00 AMDate: August 10, 2022 Time: 10:00am PDT, 1:00pm EDT The global pandemic has increased focus and scrutiny on molecular diagnostic assay development, resulting in a need for assays that provid...SEP 16, 2021 | 9:00 AMDate: September 16, 2021 Time: 9:00am (PDT), 12:00pm (EDT) For diagnostic testing, proper sample collection and transport play a pivotal role in the accurate and timely identification of a p...SEP 14, 2021 | 7:00 AMDate: September 14, 2021 Time: 7am PDT, 10am EDT, 4pm CEST A conventional thermal cycler has long been a commodity product in the lab and end-point PCR techniques can be completed almost wit...MAY 18, 2021 | 8:00 AMDate: May 18, 2021 Time: 8:00am (PST) The global pandemic has caused an increased focus and scrutiny on molecular diagnostic assay development, resulting in a need for assays that provide qu...
OCT 13, 2022 | 9:00 AM
First Broadcast: Date: October 12, 2022 Time: 8:00am PDT, 11:00am EDT Second Broadcast: Date: October 12, 2022 Time: 9:00am SGT The new Embedded CryoSPARC Live, now fully integrated with t...
Speaker:
Julio Ortiz
, Edward Pryor, PhD
, Ali Punjani
Presented at: Thermo Fisher Scientific - Electron Microscopy Webinars
Sponsored By: Thermo Fisher Scientific
Sponsored By: Thermo Fisher Scientific
AUG 10, 2022 | 10:00 AM
Date: August 10, 2022 Time: 10:00am PDT, 1:00pm EDT The global pandemic has increased focus and scrutiny on molecular diagnostic assay development, resulting in a need for assays that provid...
SEP 16, 2021 | 9:00 AM
Date: September 16, 2021 Time: 9:00am (PDT), 12:00pm (EDT) For diagnostic testing, proper sample collection and transport play a pivotal role in the accurate and timely identification of a p...
SEP 14, 2021 | 7:00 AM
Date: September 14, 2021 Time: 7am PDT, 10am EDT, 4pm CEST A conventional thermal cycler has long been a commodity product in the lab and end-point PCR techniques can be completed almost wit...
MAY 18, 2021 | 8:00 AM
Date: May 18, 2021 Time: 8:00am (PST) The global pandemic has caused an increased focus and scrutiny on molecular diagnostic assay development, resulting in a need for assays that provide qu...
MAY 11, 2021 | 10:00 AM
Date: May 11, 2021 Time: 10:00zm PDT Your samples are some of the most valuable assets in the laboratory. After spending countless hours on extraction and preparation, your conclusions could...
Speaker:
Paulina Kocjan
, Kate Meola
, Zareh Zurabyan
MAR 17, 2021 | 8:00 AM
Date: March 17, 2021 Time: 08:00am (PST) Research focused on SARS-CoV-2 has become a primary focus in genomic and molecular biology fields. With a constantly changing field with new methods...
FEB 24, 2021 | 10:00 AM
DATE: February 24, 2021 TIME: 10am PST Automated lab instruments such as liquid handlers and cell sorters are increasingly common in all types of laboratories, driving fast results for labor...
SEP 03, 2020 | 9:00 AM
DATE: September 3, 2020 TIME: 09:00am PT, 12:00pm ET xxx Learning Objectives: xxx Webinars will be available for unlimited on-demand viewing after live event. LabRoots is approved as a provi...
-
FEB 08, 2017 | 6:00 AM PSTThe 6th annual, two-day international, Laboratory Animal Science Virtual Event Series (LAS) is now available On Demand!This is a premier online-only conference focused on laboratory ani...SEP 02, 2015 | 6:00 AM PDTWelcome to Labroots 1st Annual Event in the Microbiology Virtual Event Series free online conference! Microbiology is the study of microscopic organisms...FEB 04, 2015 | 6:00 AM PSTC.E. CREDITSLabroots, Inc. is pleased to announce the annual, two-day international, virtual Laboratory Animal Science (LAS) BioConference Live that will take place on February 4th and 5th, 2015. This is...FEB 05, 2014 | 6:00 AM PSTC.E. CREDITSThis event is now apart of the Neuroscience Virtual Event Series. The Veterinary Bioscience Institute and LabRoots, Inc. are pleased to announce the annual, two-day international, event in t...
FEB 08, 2017
| 6:00 AM PST
The 6th annual, two-day international, Laboratory Animal Science Virtual Event Series (LAS) is now available On Demand!This is a premier online-only conference focused on laboratory ani...
SEP 02, 2015
| 6:00 AM PDT
Welcome to Labroots 1st Annual Event in the Microbiology Virtual Event Series free online conference! Microbiology is the study of microscopic organisms...
FEB 04, 2015
| 6:00 AM PST
C.E. CREDITS
Labroots, Inc. is pleased to announce the annual, two-day international, virtual Laboratory Animal Science (LAS) BioConference Live that will take place on February 4th and 5th, 2015. This is...
FEB 05, 2014
| 6:00 AM PST
C.E. CREDITS
This event is now apart of the Neuroscience Virtual Event Series. The Veterinary Bioscience Institute and LabRoots, Inc. are pleased to announce the annual, two-day international, event in t...